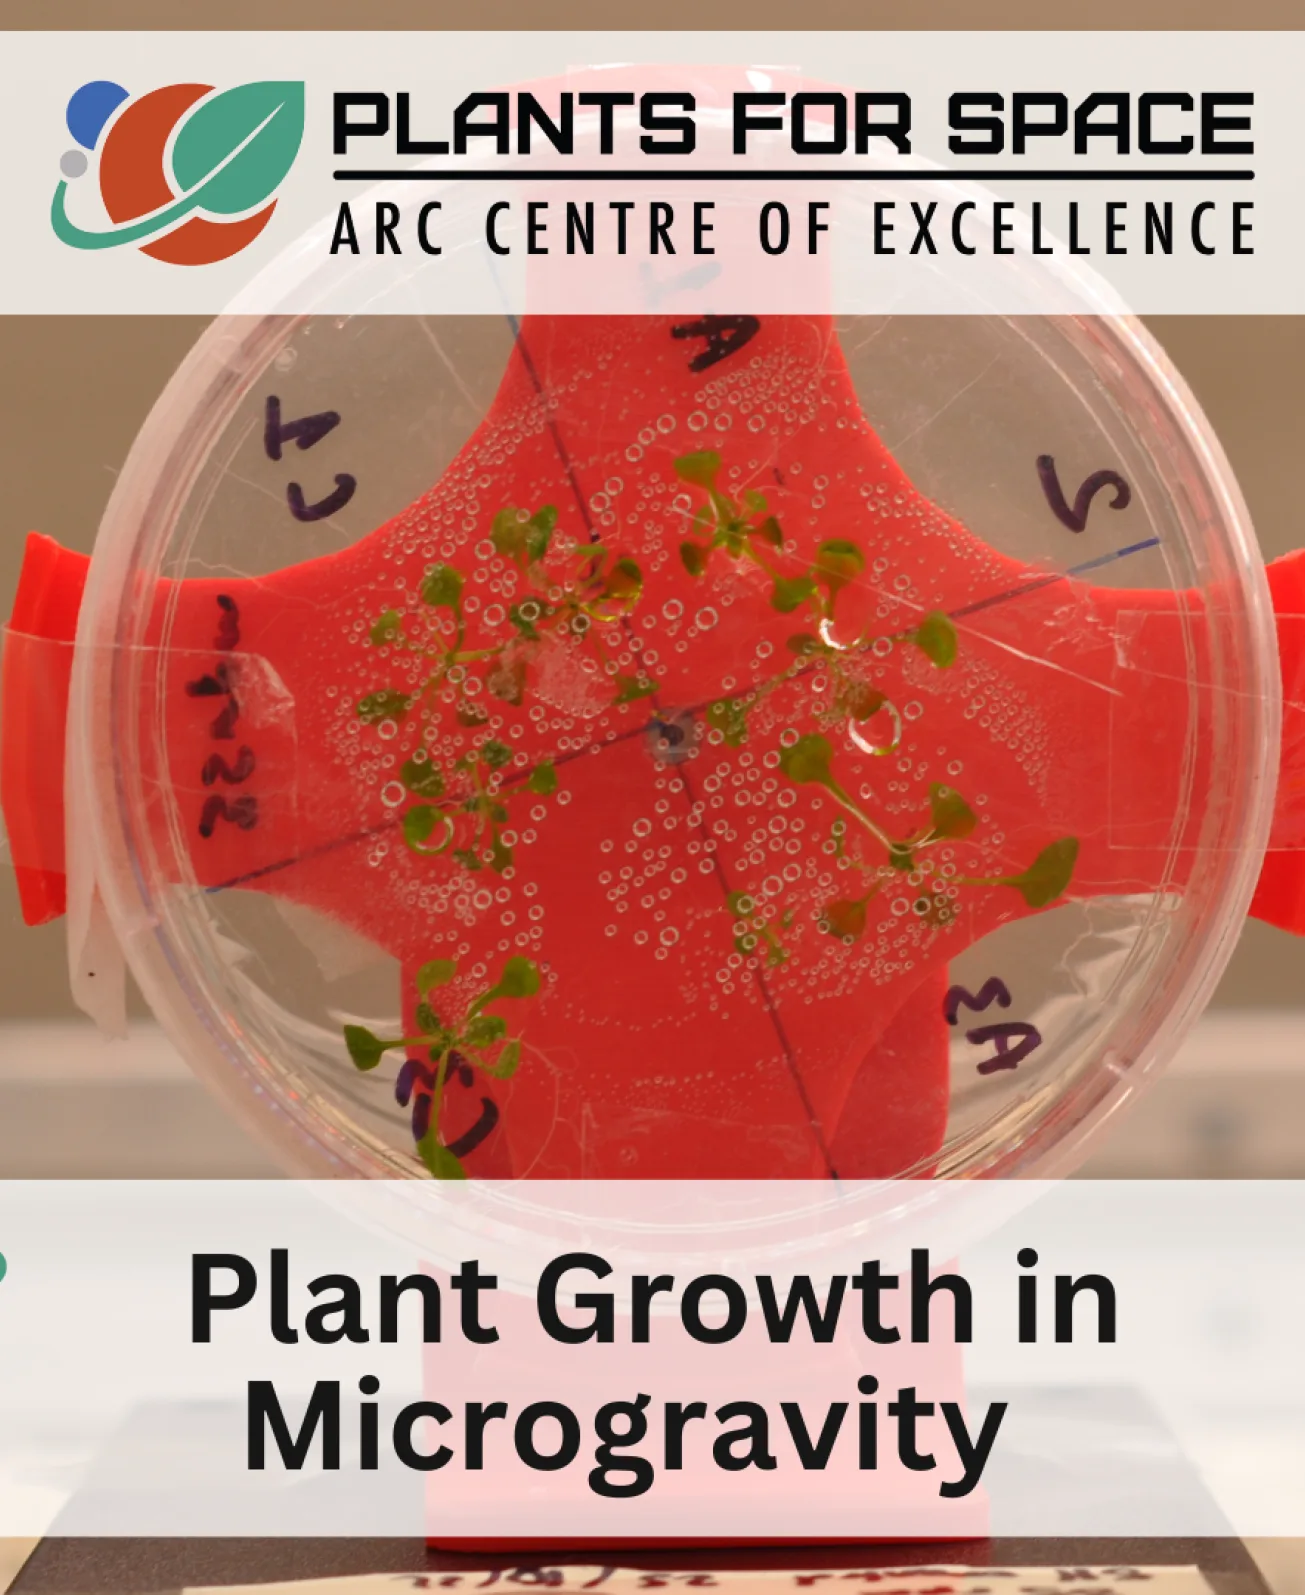

Plant Growth in Microgravity
Download Resources
This Plants for Space experimental protocol enables students to explore how plants sense and respond to gravity by modelling microgravity conditions using a classroom clinostat. Drawing directly on contemporary plant science research, the resource leads teachers and students through the preparation of agar growth media, seed sterilisation and planting, clinostat setup, and systematic observation of root and shoot development. Designed for secondary school classrooms, the protocol emphasises safe laboratory practice, reproducibility, and quantitative measurement, allowing students to compare normal Earth gravity growth with simulated microgravity conditions. Through guided observations and data collection, students gain insight into plant physiology, gravity sensing, and the challenges of growing plants for future space missions, while engaging with authentic research methods used by Plants for Space scientists.